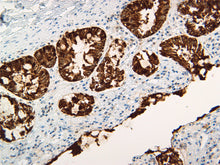
Load image into Gallery viewer, Pan Cytokeratin

Description: This antibody cocktail is a broad-spectrum pan-cytokeratin marker that stains cytokeratins present in normal and abnormal animal tissues with high sensitivity for recognizing epithelial cells and carcinomas.
Unlike other pan-cytokeratin markers, like [AE-1/AE-3], that only stain a subset of all cytokeratins, this cocktail stains all 20 human cytokeratins (CK1-CK20).
Pan-cytokeratin markers have been shown useful for:
- Differentiate epithelial tumors from non-epithelial tumors
- Characterizing the source of various neoplasms
- Study the distribution of cytokeratin containing cells in the epithelia during normal development and the development of epithelial neoplasms
Catalog: VMAB006
Clone: CHMP098
Species Reactivity: Cat and Dog
Source: Recombinant Rabbit Monoclonal Cocktail
Isotype: IgG
Antigen: Human epidermal keratin
Cellular Location: Cytoplasmic
Positive Control: Skin or adenocarcinoma
References: